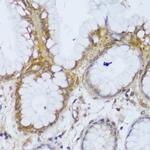
GCC2 Antibody in Immunohistochemistry (Paraffin) (IHC (P))

Search
Invitrogen
GCC2 Polyclonal Antibody
{{$productOrderCtrl.translations['antibody.pdp.commerceCard.promotion.promotions']}}
{{$productOrderCtrl.translations['antibody.pdp.commerceCard.promotion.viewpromo']}}
{{$productOrderCtrl.translations['antibody.pdp.commerceCard.promotion.promocode']}}: {{promo.promoCode}} {{promo.promoTitle}} {{promo.promoDescription}}. {{$productOrderCtrl.translations['antibody.pdp.commerceCard.promotion.learnmore']}}
图: 1 / 6
GCC2 Antibody (PA5-89457) in IHC (P)

Please note: We are reviewing Western blot images included in the antibody testing data in our catalog, including those provided by third parties. Unless expressly labeled or annotated as “raw-unedited”, Western blot images included in the antibody testing data in our catalog may have been edited, optimized or otherwise adjusted for presentation.
产品信息
PA5-89457
种属反应
已发表种属
宿主/亚型
分类
类型
抗原
偶联物
形式
浓度
规格
纯化类型
保存液
内含物
保存条件
运输条件
RRID
产品详细信息
Immunogen sequence: MEDLVQDGVA SPATPGTGKS KLETLPKEDL IKFAKKQMML IQKAKSRCTE LEKEIEELRS KPVTEGTGDI IKALTERLDA LLLEKAETEQ QCLSLKKENI KMKQEVEDSV TKMGDAHKEL EQSHINYVKE IENLKNELMA VRSKYSEDKA NLQKQLEEAM NTQLELSEQL KFQNNSEDNV KKLQEEIEKI RPGFEEQILY LQKQLDATTD EKKETVTQLQ NIIEANSQHY QKNINSLQEE LLQLKAIHQE EVKELMCQIE ASAKEHEAEI NKLNELKENL VKQCEASEKN IQKKYECELE; Positive Samples: HeLa, LO2, 22Rv1, Raji, SGC-7901, 293T; Cellular Location: Cytoplasm, Golgi apparatus, Peripheral membrane protein, trans-Golgi network membrane
靶标信息
The protein encoded by this gene is a peripheral membrane protein localized to the trans-Golgi network. It is sensitive to brefeldin A. This encoded protein contains a GRIP domain which is thought to be used in targeting. Alternative splicing results in multiple transcript variants.
⚠WARNING: This product can expose you to chemicals including mercury, which is known to the State of California to cause birth defects or other reproductive harm. For more information go to www.P65Warnings.ca.gov.
仅用于科研。不用于诊断过程。未经明确授权不得转售。
生物信息学
蛋白别名: 185 kDa Golgi coiled-coil protein; GCC185; GRIP and coiled-coil domain-containing protein 2
基因别名: 0610043A03Rik; 2210420P05Rik; 2600014C01Rik; AW112121; Gcc2; Kiaa0336; mKIAA0336
UniProt ID: (Mouse) Q8CHG3
Entrez Gene ID: (Mouse) 70297




